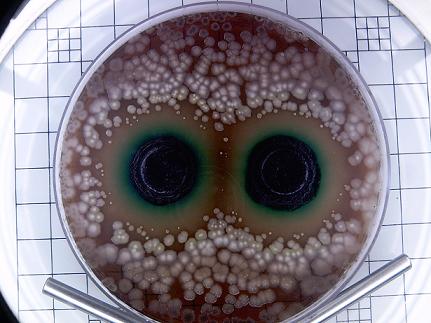
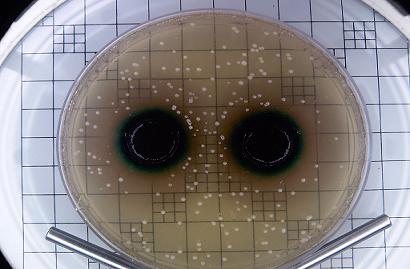

- Infecţia urinară este una dintre condiţiile patologice frecvente, întâlnită cu incidenţă mai mare la femei, din cauza particularităţilor anatomice, în special vecinătatea între orificiul urinar şi anus.
- 50% dintre femei suferă cel puţin o dată în viaţă de o formă de infecţie urinară, agentul patogen cel mai frecvent implicat fiind bacteria Escherichia coli, responsabilă de producerea a 85% dintre infecţii.
- Infecţiile urinare sunt favorizate de refluxul ureteral, expunerea excesivă la frig, litiaza renală, infecţiile genitale, diabet.
Pentru prevenirea şi tratarea infecţiilor urinare, Fiterman Pharma a creat Uractiv capsule.
- URACTIV capsule conţine cantităţi atent şi corect evaluate de: extract de strugurii ursului (Arctostaphylos uva ursi), standardizat în arbutină 20% - 175 mg şi albastru de metilen (Methylthioninium Chloride) - 15 mg.
- Albastru de metilen (Methylthioninium Chloride) este un principiu farmaceutic folosit, în mod tradiţional, în prevenirea şi tratarea infecţiilor urinare, datorită proprietăţilor dezinfectante, antiseptice şi antibacteriene la nivelul tractului urinar.
- Strugurii ursului (Arctostaphylos uva ursi) este o plantă utilizată de secole de popoarele din zona rece a emisferei nordice pentru tratarea infecţiilor urinare. Studiile clinice au confirmat eficacitatea acesteia, acţiunea fiind asociată arbutinei, component major din frunzele plantei, căruia i se datorează efectul antimicrobian şi antiinflamator.
- Uractiv este indicat în tratamentul afecţiunilor inflamatorii moderate şi uşoare ale tractului urinar inferior: cistite, uretrite, în prevenirea infecţiilor urinare recidivante, în prevenirea extinderii infecţiei la nivelul tractului urinar superior precum şi a complicaţiilor, în tratamentul microlitiazei renale.
CUM ACŢIONEAZĂ URACTIV
Uractiv acţionează ca un bactericid, antiinflamator şi diuretic. Prin cumulul acţiunilor principiilor active se realizează diminuarea rapidă a simptomatologiei:
- Calmarea durerilor şi iritaţiei de la urinare
- Distrugerea şi eliminarea bacteriilor responsabile de infecţia urinară
- Eliminarea microcalculilor şi prevenirea formării litiazei urinare
- Limpezirea urinei şi reducerea mirosului neplăcut cauzat de infecţii
- Prevenirea recidivelor şi complicaţiilor
- Albãstreste urina datoritã albastrului de metilen.
Inhibarea antimicrobianã a levurii Candida albicans (in locul de 0,26 x107 UFC/ml) în mediu solid de cãtre URACTIV.
Inhibarea antimicrobianã a levurii Candida albicans (inocul de 0,26 x107 UFC/ml) în mediu solid de cãtre URACTIV
Rezultatele testelor de laborator au arătat că URACTIV are acţiune bactericidă împotriva Escherichia coli, cel mai frecvent incriminată pentru apariţia infecţiilor urinare (85% din cazuri), dar şi asupra levurii Candida albicans.
Inhibarea antimicrobiană a Escherichia coli (inocul de 0,75 x107 UFC/ml) în mediu solid de către URACTIV.
Inhibarea antimicrobiană a levurii Candida albicans (inocul de 0,26 x107 UFC/ml) în mediu solid de către URACTIV.
www.fitermanpharma.ro
www.facebook.com/LaboratoareleFiterman

pantia livia
dupa epuizarea celor 14 zile la cat timp se poate relua tratamentul?
Nov. 7, 2016, 5:48 p.m.Oanea Marusia
Buna ziua,am luat tratament cu uractiv forte 14 zile,.Am o uretrită ,cistita ,fac și pielonefrita provocate de e.coli..Ce pot sa iau o perioada mai îndelungată din gama uractiv?am luat și 7zile ciprofloxacina ,așa a indicat antibiograma.M-am saturat de antibiotice!!!La cât timp pot sa iau iarăși uractiv forte?
Oct. 22, 2017, 3:13 p.m.